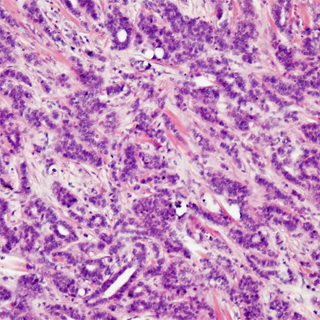
BreastCare Pathologie

Pathologie
Egal wie verdächtig ein Tastbefund auch sein mag,
selbst wenn die Bildgebung noch so problematisch wirkt.
Die Gewissheit schafft erst der Pathologe.
Und nicht nur das. Er legt das Fundament jeder Behandlung.
Weiter
Egal wie verdächtig ein Tastbefund auch sein mag,
selbst wenn die Bildgebung noch so problematisch wirkt.
Die Gewissheit schafft erst der Pathologe.
Und nicht nur das. Er legt das Fundament jeder Behandlung.
Weiter